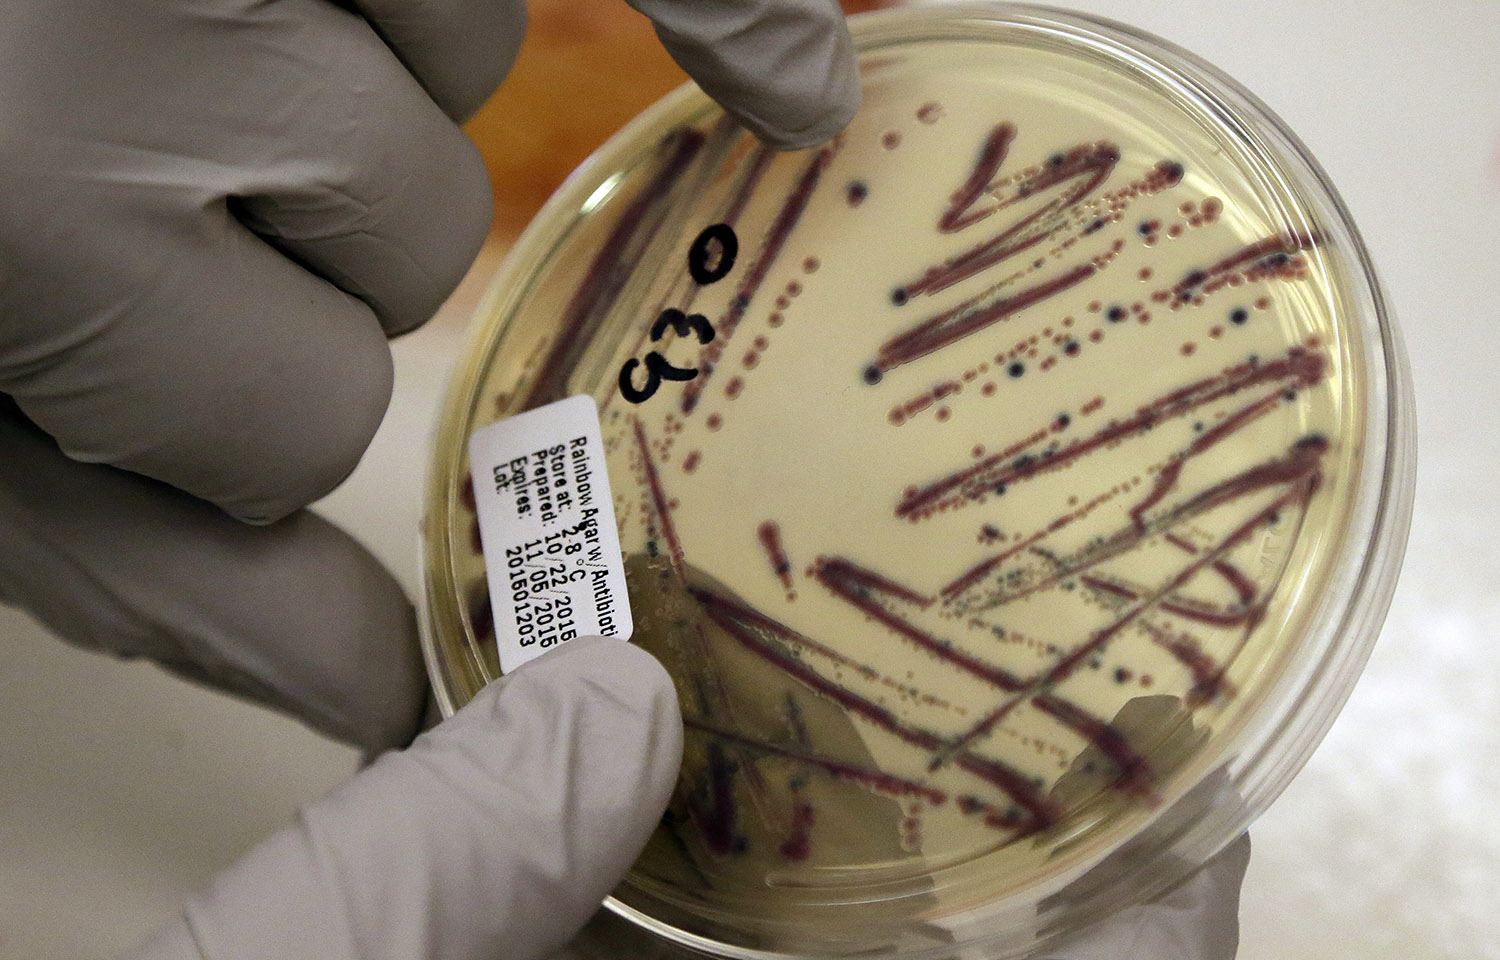
Deadly superbug found in U.S.

A superbug that is resistant to a vital antibiotic of last resort has reached the U.S.
The superbug strain of the bacteria E. coli was found in a 49-year-old woman at a clinic in Pennsylvania last month, according to a study from the American Society for Microbiology.
Recommended Stories
The superbug was identified in the United Kingdom in 2008, and this is the first U.S. case of the strain. What makes the superbug unique is that it is resistant to colistin, which is employed by doctors as a last resort against multi-drug-resistant strains of bacteria.
Researchers were perplexed that the woman who got the bacteria in Pennsylvania had no travel history within the past five months.
“Continued surveillance to determine the true frequency for this gene in the USA is critical,” the study said.
The Centers for Disease Control and Prevention estimates that at least 2 million people get infected every year with antibiotic-resistant bacteria, and at least 23,000 people die from such infections.